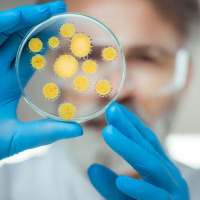
Medical Progress and Private Money

Synopsis
The Philanthropy Roundtable’s mission is to foster excellence in philanthropy, to protect philanthropic freedom, to assist donors in achieving their philanthropic intent, and to help donors advance liberty, opportunity, and personal responsibility in America and abroad. Follow Karl Zinsmeister's podcast, Sweet Charity, for short weekly stories about how private giving solves public problems.
Episodes
-
The Humanitarian Habits of Religious People
06/12/2019 Duration: 05minAmerica’s extraordinary generosity and historic faith are closely linked.
-
American Giving Viewed from Abroad
17/10/2019 Duration: 13minA recent speaking trip to Australia reminds us how unusual U.S. philanthropy is
-
The Backlash Against School Reform
18/07/2019 Duration: 10minEnemies of innovation have got the upper hand right now. Here’s a Throwback Thursday reminder of why that’s not good—and won’t last.
-
Meet the World’s Largest Musical Instrument
06/06/2019 Duration: 12minVoluntary givers created it, restored it, and are saving it for the future
-
A Walk Through Some Nation-changing Churches
03/12/2018 Duration: 08minGiving thanks for Boston’s charitable houses of worship.
-
Some Common Criticisms of Philanthropy — Part 3
12/09/2018 Duration: 07min…and a few quick answers. Part 3 of three podcasts.
-
Some Common Criticisms of Philanthropy — Part 2
16/08/2018 Duration: 08minSome common criticisms of philanthropy…and a few quick answers. Part 2 of three podcasts.
-
Some Common Criticisms of Philanthropy
12/07/2018 Duration: 07min…and a few quick answers. Part 1 of three podcasts.
-
Radical School for a Red-hot Problem
14/06/2018 Duration: 06minA new charter boarding school in DC educates kids facing stiff odds
-
-
-
Gem of a Donation
05/04/2018 Duration: 06minA great natural wonder and object of beauty is preserved by a generous couple.
-
Private Schools for the Poor?
14/03/2018 Duration: 08minIn the world’s most destitute neighborhoods, it’s a real thing.
-
Medical Progress and Private Money
13/02/2018 Duration: 05minWherever the health sciences are progressing fastest today, it’s often donated money that is pushing the frontier.
-
Secret Codes & Philanthropy
17/01/2018 Duration: 06minAmerica’s world-leading expertise in code-making and code-breaking grows out of a charitable project, believe it or not.
-
Reinventing Public Universities
18/12/2017 Duration: 06minPhilanthropy can have a leading role in pulling state-run colleges away from bureaucracy and low standards.
-
A Joint Venture in Goodness
27/11/2017 Duration: 06minEvangelical Christians and faithful Jews team up to help the neediest.
-
Benjamin Rush, Hall of Fame Philanthropist
23/10/2017 Duration: 06minMeet a top doctor, turned political founder, turned charity pioneer
-
Arts Philanthropy in the North Woods Part II
10/10/2017 Duration: 07minIs giving money to art elitist, even irresponsible, in a world with many pressing needs? (Part TWO of two podcasts)
-
Arts Philanthropy in the North Woods Part I
26/09/2017 Duration: 04minIs giving money to art elitist, even irresponsible, in a world with many pressing needs? (Part ONE of two podcasts)